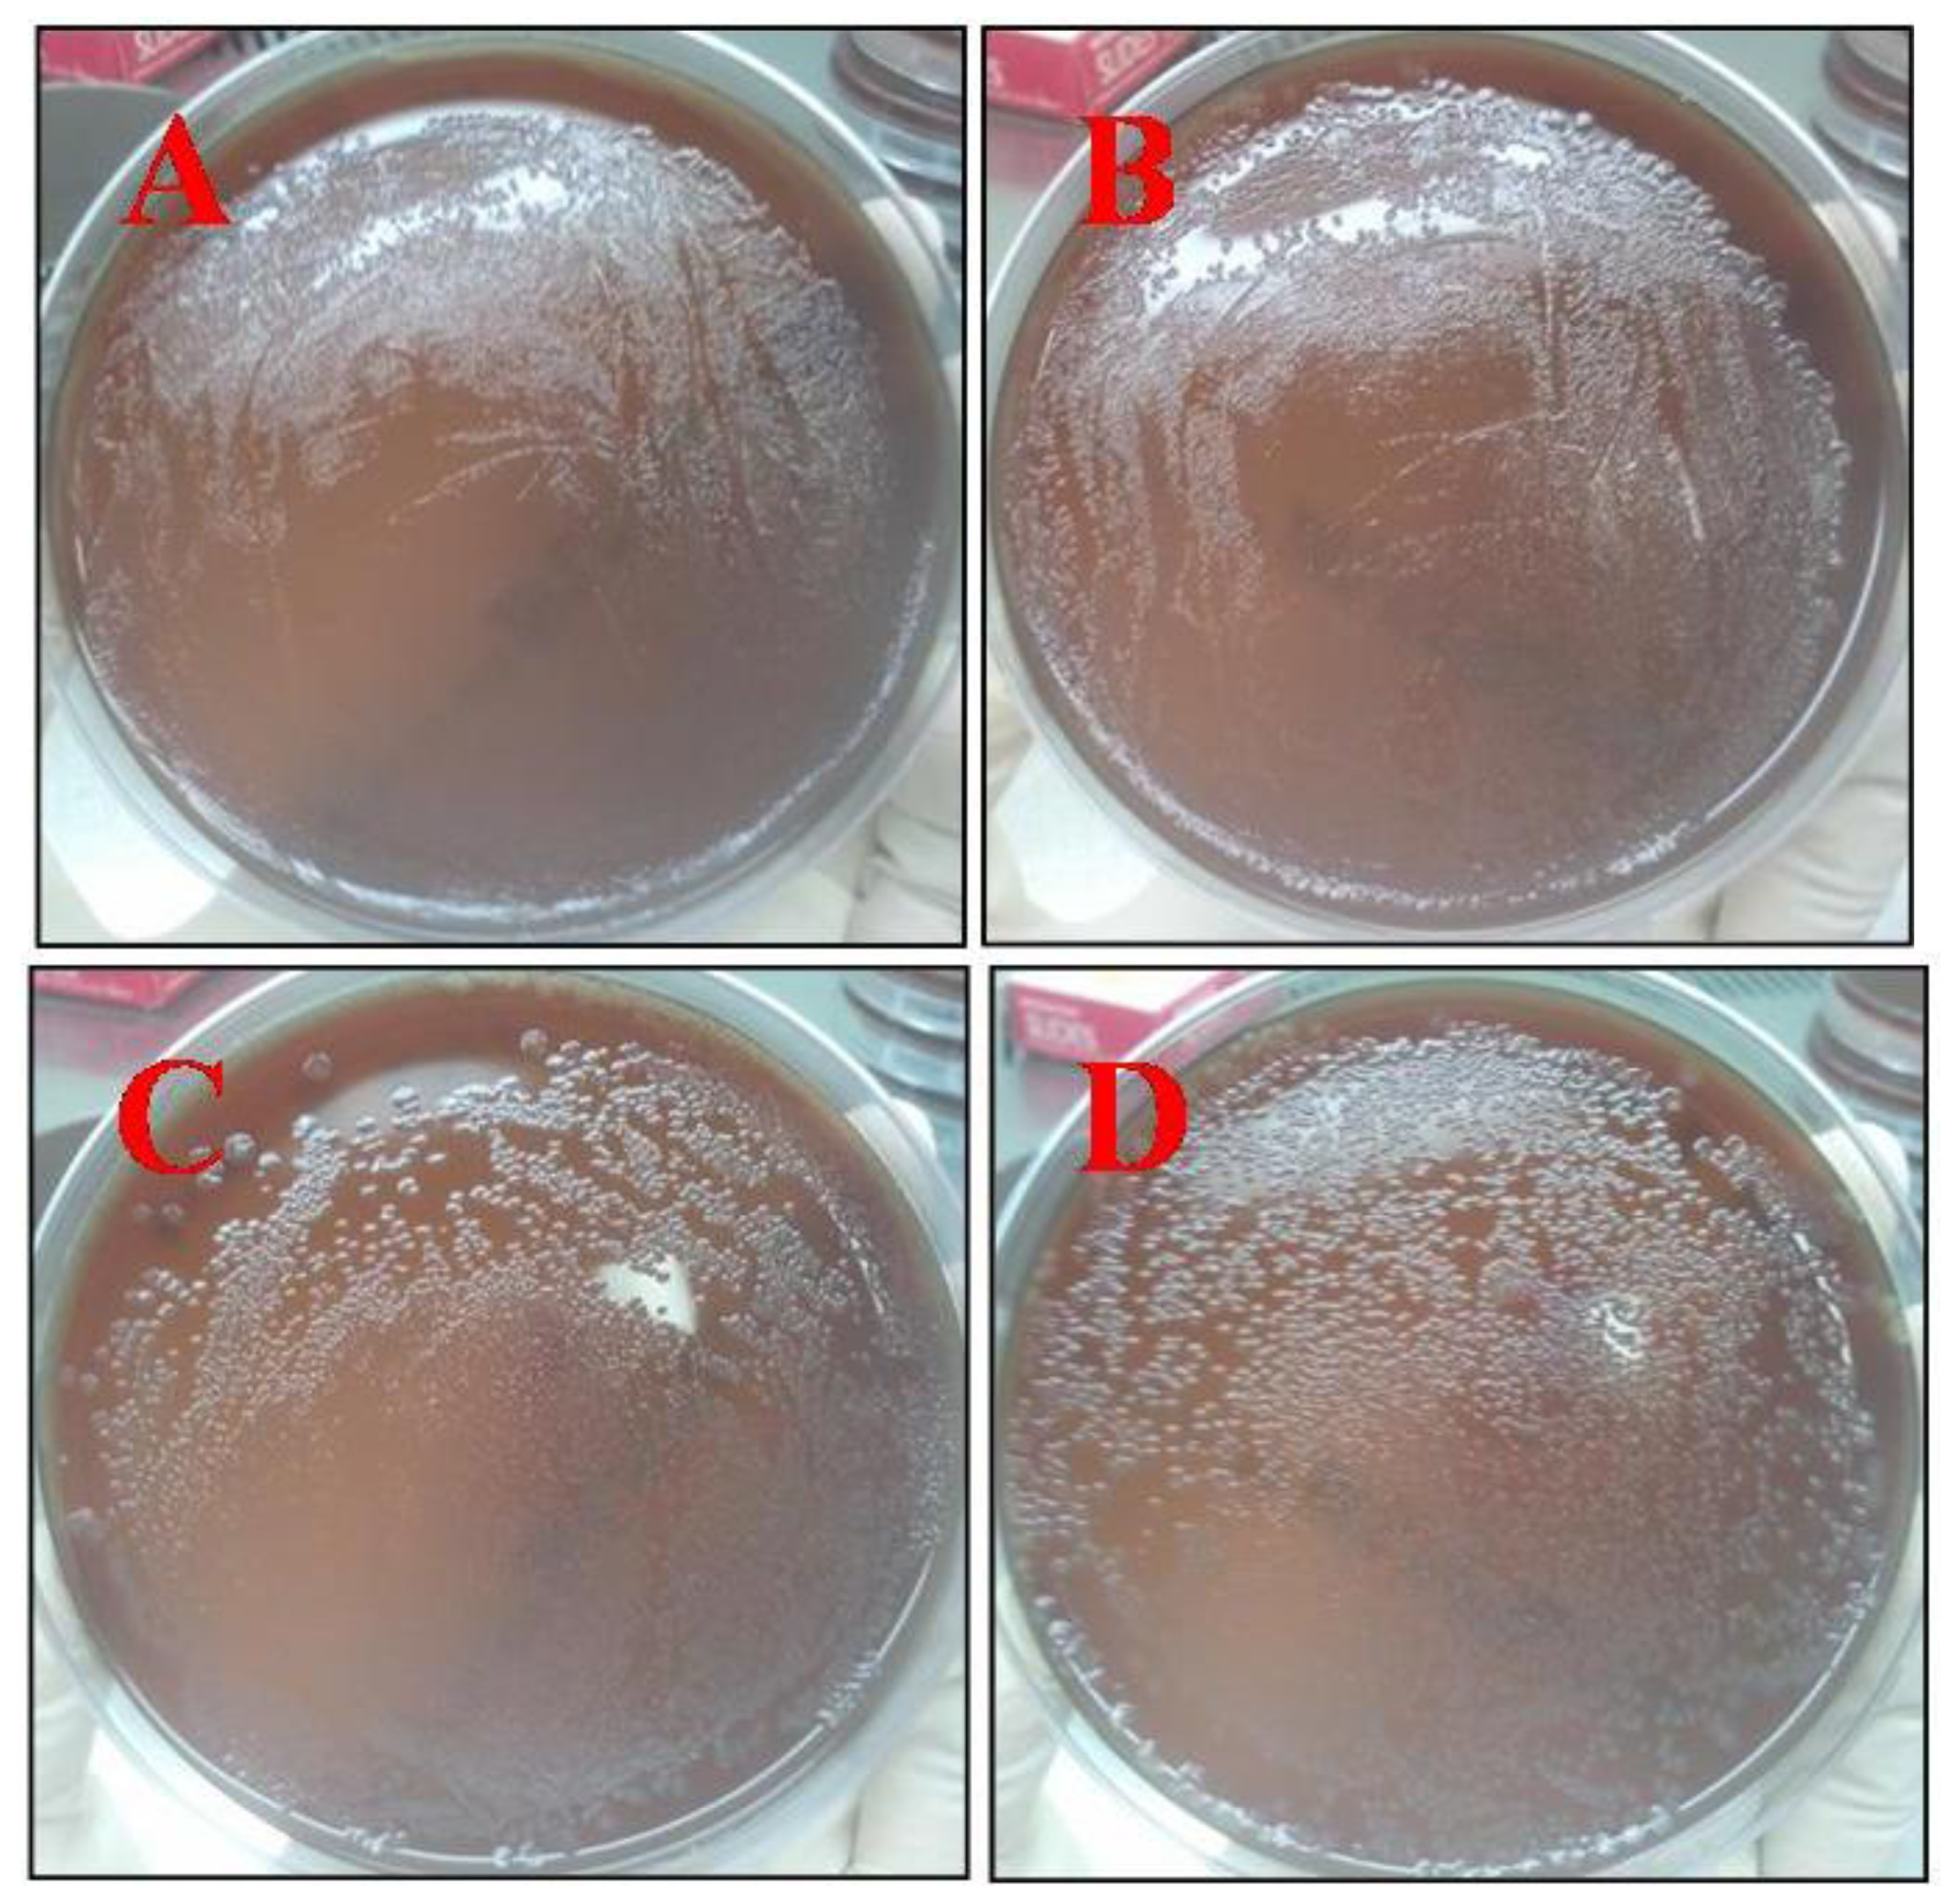
Ijms 13 06102f8

Physiochemical, Optical and Biological Activity of Chitosan-Chromone Derivative for Biomedical Applications
Abstract
:1. Introduction
2. Results and Discussion
2.1. FTIR Spectra
2.2. X-ray Diffraction (XRD) Study
2.3. Thermal Analysis (TGA, DSC)
2.4. Scanning Electron Microscopy (SEM)
2.5. Photoluminescence Properties (PL)
2.6. UV-Vis Absorption Spectrum and Circular Dichroism (CD) Spectrum
2.7. Antimicrobial Study
2.8. Assay for Cellular Cytotoxicity, Proliferation, and Viability
3. Experimental Section
3.1. Synthesis of 4-oxo-4H-Chromene-3-Carbaldehyde
3.2. Preparation of Chitosan-Chromone Derivative
3.3. Characterization Methods
3.3.1. Antimicrobial Activity Assay
3.3.2. Assay for Cellular Cytotoxicity, Proliferation and Viability
4. Conclusions
Acknowledgments
References
- Zhang, Y.; Tao, L.; Li, S.; Wei, Y. Synthesis of multiresponsive and dynamic chitosan-based hydrogels for controlled release of bioactive molecules. Biomacromolecules 2011, 12, 2894–2901. [Google Scholar]
- Kumar, S.; Nigam, N.; Ghosh, T.; Dutta, P.K.; Yadav, R.S.; Pandey, A.C. Preparation, characterization, and optical properties of a chitosan-anthraldehyde crosslinkable film. J. Appl. Polym. Sci 2010, 115, 3056–3062. [Google Scholar]
- Kumar, S.; Dutta, P.K.; Sen, P. Preparation and characterization of optical property of crosslinkable film of chitosan with 2-thiophenecarboxaldehyde. Carbohydr. Polym 2010, 80, 564–570. [Google Scholar]
- Shi, B.; Shen, Z.; Zhang, H.; Bi, J.; Dai, S. Exploring N-imidazolyl-O-carboxymethyl chitosan for high performance gene delivery. Biomacromolecules 2012, 13, 146–153. [Google Scholar]
- Lord, M.S.; Cheng, B.; McCarthy, S.J.; Jung, M.; Whitelock, J.M. The modulation of platelet adhesion and activation by chitosan through plasma and extracellular matrix proteins. Biomaterials 2011, 32, 6655–6662. [Google Scholar]
- Rejinold, N.S.; Nair, A.; Sabitha, M.; Chennazhi, K.P.; Tamura, H.; Nair, S.V.; Jayakumar, R. Synthesis, characterization and in vitro cytocompatibility studies of chitin nanogels for biomedical applications. Carbohydr. Polym 2012, 87, 943–949. [Google Scholar]
- Anitha, A.; Divya Rani, V.V.; Krishna, R.; Sreeja, V.; Selvamurugan, N.; Nair, S.V.; Tamura, H.; Jayakumar, R. Synthesis, characterization, cytotoxicity and antibacterial studies of chitosan, O-carboxymethyl and N,O-carboxymethyl chitosan nanoparticles. Carbohydr. Polym 2009, 78, 672–677. [Google Scholar]
- Jayakumar, R.; Menon, D.; Manzoor, K.; Nair, S.V.; Tamura, H. Biomedical applications of chitin and chitosan based nanomaterials—A short review. Carbohydr. Polym 2010, 82, 227–232. [Google Scholar]
- Thein-Han, W.W.; Misra, R.D.K. Biomimetic chitosan-nanohydroxyapatite composite scaffolds for bone tissue engineering. Acta Biomater 2009, 5, 1182–1197. [Google Scholar]
- Muzzarelli, R.A.A.; Mattioli-Belmonte, M.; Pugnaloni, A.; Biagini, G. Biochemistry, Histology and Clinical Uses of Chitins and Chitosans in Wound Healing. In Chitin and Chitinases; Jollès, P., Muzzarelli, R.A.A., Eds.; Birkhäuser; Basel, Switzerland, 1999; Volume 87, pp. 251–264. [Google Scholar]
- Depan, D.; Girase, B.; Shah, J.S.; Misra, R.D.K. Structure-process-property relationship of the polar graphene oxide-mediated cellular response and stimulated growth of osteoblasts on hybrid chitosan network structure nanocomposite scaffolds. Acta Biomater 2011, 7, 3432–3445. [Google Scholar]
- Depan, D.; Venkatasurya, P.K.C.; Girase, B.; Misra, R.D.K. Organic/inorganic hybrid network structure nanocomposite scaffolds based on grafted chitosan for tissue engineering. Acta Biomater 2011, 7, 2163–2175. [Google Scholar]
- Thein-Han, W.W.; Saikhun, J.; Pholpramoo, C.; Misra, R.D.K.; Kitiyanant, Y. Chitosan-gelatin scaffolds for tissue engineering: Physico-chemical properties and biological response of buffalo embryonic stem cells and transfectant of GFP-buffalo embryonic stem cells. Acta Biomater 2009, 5, 3453–3466. [Google Scholar]
- Mali, S.; Misra, R.D.K.; Somani, M.C.; Karjalainen, L.P. Biomimetic nanostructured coatings on nano-grained/ultrafine-grained substrate: Microstructure, surface adhesion strength, and biosolubility. Mater. Sci. Eng. C 2009, 29, 2417–2427. [Google Scholar]
- Maganti, N.; Venkatsurya, P.K.C.; Theinhan, W.W.; Pesacreta, T.C.; Misra, R.D.K. Structure process property relationship of biominetic chitosan based nanocomposite scaffolds for tissue engineering: Biological, physicochemical, and mechanical functions. Adv. Eng. Mater 2011, 13, B108–B122. [Google Scholar]
- Misra, R.D.K. Chitosan as a scaffold matrix in tissue engineering. Mater. Sci. Technol 2008, 34, 1062–1075. [Google Scholar]
- Yuan, Q.; Venkatasubramanian, R.; Hein, S.; Misra, R.D.K. A stimulus-responsive magnetic nanoparticle drug carrier: Magnetite encapsulated by chitosan-grafted-copolymer. Acta Biomater 2008, 4, 1024–1037. [Google Scholar]
- Yuan, Q.; Shah, J.; Hein, S.; Misra, R.D.K. Controlled and extended drug release behavior of chitosan-based nanoparticle carrier. Acta Biomater 2010, 6, 1140–1148. [Google Scholar]
- Depan, D.; Shah, J.; Misra, R.D.K. Controlled release of drug from folate-decorated and graphene mediated drug delivery system: Synthesis, loading efficiency, and drug release response. Mater. Sci. Eng. C 2011, 31, 1305–1312. [Google Scholar]
- Khor, E.; Lim, L.Y. Implantable applications of chitin and chitosan. Biomaterials 2003, 24, 2339–2349. [Google Scholar]
- Muzzarelli, R.A.A.; Mattioli-Belmonti, M.; Tiez, C.; Biagini, G.; Ferioli, G.; Brunelli, M.A.; Fini, M.; Giardino, R., II; ari, P.; Biagini, G. Stimulatory effect on bone formation exerted by a modified chitosan. Biomaterials 1994, 15, 1075–1081. [Google Scholar]
- Mooney, D.J.; Baldwin, D.F.; Suh, N.P.; Vacanti, J.P.; Langer, R. Novel approach to fabricate porous sponges of poly (D,L-lactic-co-glycolic acid) without the use of organic solvents. Biomaterials 1996, 17, 1417–1422. [Google Scholar]
- Fradet, G.; Brister, S.; Mulder, D.S.; Lough, J.; Averbach, B.L. Chitin in Nature and Technology; Muzzarelli, R., Jeuniaux, C., Gooday, G.W., Eds.; Plenum Press: New York, NY, USA, 1986; p. 443. [Google Scholar]
- Kumar, S.; Dutta, P.K.; Koh, J. A physiocochemical and biological study of novel chitosan-chloroquinoline derivative for biomedical applications. Int. J. Biol. Macromol 2011, 49, 356–361. [Google Scholar]
- Kumar, S.; Dutta, J.; Dutta, P.K. Preparation, characterization and optical property of chitosan-phenothiazine derivative by microwave assisted synthesis. J. Macromol. Sci. Pure Appl. Chem 2009, 46, 1095–1102. [Google Scholar]
- Jayakumar, R.; Prabharan, M.; Nair, S.V.; Tamura, H. Novel chitin and chitosan nanofibers in biomedical applications. Biotechnol. Adv 2010, 79, 142–150. [Google Scholar]
- Nam, D.H.; Lee, K.Y.; Moon, C.S.; Lee, Y.S. Synthesis and anticancer activity of chromone-based analogs of lavendustin A. Eur. J. Med. Chem 2010, 45, 4288–4292. [Google Scholar]
- Valenti, P.; Bisi, A.; Rampa, A.; Belluti, F.; Gobbi, S.; Zampiron, A.; Carrara, M. Synthesis and biological activity of some rigid analogues of flavones-8-acetic acid. Bioorg. Med. Chem 2000, 8, 239–246. [Google Scholar]
- Lin, L.C.; Kuo, Y.C.; Chou, C.J. Cytotoxic biflavonoids from Selaginella delicatula. J. Nat. Prod 2000, 63, 627–630. [Google Scholar]
- Shi, Y.Q.; Fukai, T.; Sakagami, H.; Chang, W.J.; Yang, P.Q.; Wang, F.P.; Nomura, T. Cytotoxic flavonoids with isoprenoid groups from morus mongolica. J. Nat. Prod 2001, 64, 181–188. [Google Scholar]
- Larget, R.; Lockhart, B.; Renard, P.; Largeron, M. A convenient extension of the Wessly-Moser rearrangement for the synthesis of substituted alkylaminoflavones as neuroprotective agents in vitro. Bioorg. Med. Chem. Lett 2000, 10, 835–838. [Google Scholar]
- Groweiss, A.; Cardellins, J.H.; Boyd, M.R. HIV-inhibitory prenylated xanthones and flavones from Maclura tinctoria. J. Nat. Prod 2000, 63, 1537–1539. [Google Scholar]
- Park, H.R.; Park, K.S.; Chong, Y. 2-Arylmethylaminomethyl-5,6-dihydroxychromone derivatives with selective anti-HCV activity. Bioorg. Med. Chem. Lett 2011, 21, 3202–3205. [Google Scholar]
- Zhou, T.; Shi, Q.; Chen, C.H.; Zhu, H.; Huang, L.; Ho, P.; Lee, K.H. Anti-AIDS agents 79. Design, synthesis, molecular modelling and structure-activity relationships of novel dicamphanoyl-2′,2′-dimethyldihydropyranochromone (DCP) analogs as potent anti-HIV agents. Bioorg. Med. Chem 2010, 18, 6678–6689. [Google Scholar]
- Deng, Y.; Lee, J.P.; Ramamonjy, M.T.; Synder, J.K.; Des Etages, S.A.; Kanada, D.; Synder, M.P.; Turner, C.J. New antimicrobial flavones from Physena madagascariensis. J. Nat. Prod 2000, 63, 1082–1089. [Google Scholar]
- Khan, I.A.; Avery, M.A.; Burandt, C.L.; Goins, D.K.; Mikell, J.R.; Nash, T.E.; Azadega, A.; Walker, L.A. Antigiardial activity of isoflavones from Dalbergia frutescens bark. J. Nat. Prod 2000, 63, 1414–1416. [Google Scholar]
- Ma, W.G.; Fuzzati, N.; Shao Long, L.; de Shun, G.; Hostettmann, K. Further chromones from Eriosema tuberosum. Phytochemistry 1996, 43, 1339–1343. [Google Scholar]
- Pietta, P.J. Flavonoids as antioxidants. J. Nat. Prod 2000, 63, 1035–1042. [Google Scholar]
- Thanigaimalai, P.; Lee, K.C.; Sharma, V.K.; Yun, J.H.; Kim, Y.; Jung, S.H. Design and synthesis of novel hydroxyalkylaminomethylchromones for their IL-5 inhibitory activity. Bioorg. Med. Chem 2010, 18, 4625–4629. [Google Scholar]
- Shaw, A.Y.; Chang, C.Y.; Liau, H.H.; Lu, P.J.; Chen, H.L.; Yang, C.N.; Li, H.Y. Synthesis of 2-styrylchromones as a novel class of antiproliferative agents targeting carcinoma cells. Eur. J. Med. Chem 2009, 44, 2552–2562. [Google Scholar]
- Kumar, S.; Singh, B.K.; Pandey, A.K.; Kumar, A.; Sharma, S.K.; Raj, H.G.; Prasad, A.K.; Eycken, E.V.; Parmar, V.S.; Ghosh, B. A chromone analog inhibits TNF-α induced expression of cell adhesion molecules on human endothelial cells via blocking NF-κB activation. Bioorg. Med. Chem 2007, 15, 2952–2962. [Google Scholar]
- Badawy, M.E. Chemical modification of chitosan: Synthesis and biological activity of new heterocyclic chitosan derivatives. Polym. Int 2008, 57, 254–261. [Google Scholar]
- Kumar, S.; Dutta, J.; Dutta, P.K. Preparation and characterization of N-heterocyclic chitosan derivative based gels for biomedical applications. Int. J. Biol. Macromol 2009, 45, 330–337. [Google Scholar]
- Kumar, S.; Koh, J.; Kim, H.; Gupta, M.K.; Dutta, P.K. A new chitosan-thymine conjugate: Synthesis, characterization and biological activity. Int. J. Biol. Macromol 2012, 50, 493–502. [Google Scholar]
- Xiao, Y.; Zhou, X. Synthesis and properties of a novel crosslinked chitosan resin modified by L-lysine. React. Funct. Polym 2008, 68, 1281–1289. [Google Scholar]
- Hirano, S.; Nagamura, K.; Zhang, M.; Kim, S.K.; Chung, B.G.; Yoshikawa, M.; Midorikawa, T. Chitosan staple fibers and their chemical modification with some aldehydes. Carbhydr. Polym 1999, 38, 293–298. [Google Scholar]
- Santos, J.E.; Dockal, E.R.; Cavalheiro, E.T.G. Synthesis and characterization of Schiff bases from chitosan. Carbohydr. Polym 2005, 60, 227–282. [Google Scholar]
- Van Beijnen, J.M.; Nolte, R.J.M.; Naaktgeboren, A.J.; Zwikker, J.W.; Drenth, W. Helical configuration of poly (iminomethylenes). Synthesis and CD spectra of polymers derived from optically active isocyanides. Macromolecules 1983, 16, 1679–1689. [Google Scholar]
- Cornelissen, J.J.L.M. Hierarchial transfer of stereochemical information in synthetic macromolecules. Pure Appl. Chem 2002, 74, 2021–2030. [Google Scholar]
- Thanigaimalai, P.; Hoang, T.A.; Lee, K.C.; Sharma, V.K.; Bang, S.C.; Yun, J.H.; Roh, E.; Kim, Y.; Jung, S.H. Synthesis and evaluation of novel chromone analogs for their inhibitory activity against interleukin-5. Eur. J. Med. Chem 2010, 45, 2531–2536. [Google Scholar]

| Concentration (μg/mL) | PDT (h) | r/day | Viability (%) |
|---|---|---|---|
| 0 | 21.33 a | 0.81 a | 97.53 a |
| 20 | 21.04 a | 0.82 a | 96.70 a |
| 40 | 20.48 a | 0.85 a | 97.67 a |
| 80 | 18.96 a | 0.93 a | 96.34 a |
| 120 | 20.76 a | 0.84 a | 96.81 a |
| 800 | 21.94 a | 0.78 a | 97.75 a |
© 2012 by the authors; licensee Molecular Diversity Preservation International, Basel, Switzerland. This article is an open-access article distributed under the terms and conditions of the Creative Commons Attribution license (http://creativecommons.org/licenses/by/3.0/).
Share and Cite
Kumar, S.; Koh, J. Physiochemical, Optical and Biological Activity of Chitosan-Chromone Derivative for Biomedical Applications. Int. J. Mol. Sci. 2012, 13, 6102-6116. https://doi.org/10.3390/ijms13056102
Kumar S, Koh J. Physiochemical, Optical and Biological Activity of Chitosan-Chromone Derivative for Biomedical Applications. International Journal of Molecular Sciences. 2012; 13(5):6102-6116. https://doi.org/10.3390/ijms13056102
Chicago/Turabian StyleKumar, Santosh, and Joonseok Koh. 2012. "Physiochemical, Optical and Biological Activity of Chitosan-Chromone Derivative for Biomedical Applications" International Journal of Molecular Sciences 13, no. 5: 6102-6116. https://doi.org/10.3390/ijms13056102
APA StyleKumar, S., & Koh, J. (2012). Physiochemical, Optical and Biological Activity of Chitosan-Chromone Derivative for Biomedical Applications. International Journal of Molecular Sciences, 13(5), 6102-6116. https://doi.org/10.3390/ijms13056102
